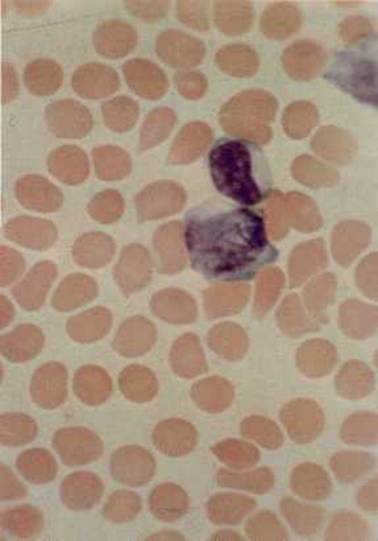

Другие названия и синонимы
Atypical mycobacterial infections.
МКБ-10 коды
|
|
Описание
Атипичная микобактериальная инфекция - комплекс гранулематозных поражений, вызываемых микобактериями, отличающимися от классических патогенов - возбудителей туберкулёза и лепры.
Клиническая картина
Туберкулёзоподобные поражения. В патологический процесс вовлекаются лёгкие, почки, кожные покровы и костно-суставная система. Часто осложняют течение эмфизематозных процессов. У 40-50% больных с иммунодефицитными состояниями вызывают генерализованные поражения.
Лимфадениты. Клинически чаще проявляются поражениями шейных лимфатических узлов (т.н. скрофулы); последние безболезненны, могут изъязвляться либо дренироваться наружу; системные проявления слабые или чаще отсутствуют.
Кожные поражения. Типичным считают инфицирование ран конечностей, полученных при ударе о стенку бассейна или любой объект на дне и берегах водоёма. Чаще наблюдают образование изъязвляющейся гранулёмы, спонтанно ограничивающейся в течение нескольких недель, в более редких случаях формируется хроническая инфекция.
Реже наблюдают хронические лёгочные поражения у лиц среднего возраста, зарегистрированные к настоящему времени повсеместно. Возможны бурситы локтевого сустава при повторных травмах и кожные поражения, цервикальные лимфадениты и синдром запястного канала у лиц с иммунодефицитами (наиболее часто после терапии гормональными препаратами).
Лимфадениты. Клинически чаще проявляются поражениями шейных лимфатических узлов (т.н. скрофулы); последние безболезненны, могут изъязвляться либо дренироваться наружу; системные проявления слабые или чаще отсутствуют.
Кожные поражения. Типичным считают инфицирование ран конечностей, полученных при ударе о стенку бассейна или любой объект на дне и берегах водоёма. Чаще наблюдают образование изъязвляющейся гранулёмы, спонтанно ограничивающейся в течение нескольких недель, в более редких случаях формируется хроническая инфекция.
Реже наблюдают хронические лёгочные поражения у лиц среднего возраста, зарегистрированные к настоящему времени повсеместно. Возможны бурситы локтевого сустава при повторных травмах и кожные поражения, цервикальные лимфадениты и синдром запястного канала у лиц с иммунодефицитами (наиболее часто после терапии гормональными препаратами).
Течение и стадии
Течение - прогрессирующее. Более чем у 20% пациентов отмечают рецидивы заболевания в течение 5 лет.
Диагностика
Методы исследования Выделение и идентификация возбудителя по скорости роста, образованию пигментов (на свету или в темноте) и патогенности для лабораторных животных AT к Mycobacterium kansasii перекрёстно реагируют с Аг Mycobacterium tuberculosis и у инфицированных лиц отмечают положительную реакцию Манту.
Дифференциальная диагностика
Дифференциальный диагноз Лепра, Туберкулёз, Боррелиоз, Чума.
Причины
Возбудители - Mycobacterium ulcerans, Mycobacterium marinum (Mycobacterium balnei), Mycobacterium kansasii, Mycobacterium avium-intracellulare, Mycobacterium xenopi, Mycobacterium szulgai, Mycobacterium scrofulaceum, Mycobacterium fortuitum, Mycobacterium malmoense.
Эпидемиология. Большинство возбудителей широко распространено в окружающей среде; некоторые обитают в воде и прибрежной зоне, вызывая заболевания у рыб, другие (например, Mycobacterium avium-intracellulare) - у птиц. Наиболее часто заражение происходит при вдыхании микобактерий, употреблении заражённых продуктов и проникновении возбудителя через микротравмы кожи и слизистых оболочек.
Эпидемиология. Большинство возбудителей широко распространено в окружающей среде; некоторые обитают в воде и прибрежной зоне, вызывая заболевания у рыб, другие (например, Mycobacterium avium-intracellulare) - у птиц. Наиболее часто заражение происходит при вдыхании микобактерий, употреблении заражённых продуктов и проникновении возбудителя через микротравмы кожи и слизистых оболочек.
Патогенез
Проникшие микобактерий фагоцитируются макрофагами и транспортируются в регионарные лимфатические узлы; фагоцитарные реакции незавершённые, и возбудитель персистирует в цитоплазме макрофагов. Воспалительная реакция незначительная, но в месте проникновения развивается первичный аффект. В динамике по ходу регионарных лимфатических путей и узлов формируется первичный комплекс, характеризующийся развитием гранулём. Микроскопия биоптатов выявляет в последних очаги неказеозного некроза, содержащие кислотоустойчивые бактерии.
Лечение
При лёгочных поражениях. Рекомендовано сочетание изониазида 600 мг, рифампицина 300 мг, стрептомицина 1 г и этамбутола 15-25 мг/кг 1 р/сут.
При поражении М. marinum - миноциклин по 100 мг каждые 12 ч в течение 6-8 нед.
При поражении М. kansasii and M. xenopi эффективна стандартная противотуберкулёзная терапия с обязательным назначением рифампицина.
Хирургическое вмешательство рекомендовано при локализованных поражениях у пациентов молодого возраста без патологии других органов и систем.
При лимфадените - у детей от 1 до 5 лет показано хирургическое лечение.
При кожных поражениях, вызванных М. marinum, - тетрациклин (1-2 r/сут) и сочетание рифампицина и этамбутола в течение 3-6 мес.
При инфекциях, вызванных ранами или инородными телами.
Хирургическая обработка раны и удаление инородного тела. Лекарственная терапия: сульфатримоксазол (50 мг/кг сут), доксициклин (200-400 мг/сут), цефокситин (200 мг/кг/ сут), амикацин (10-15 мг/сут) в течение 3-6 мес.
При диссеминированных поражениях - сочетание противотуберкулёзных средств (как при лёгочных поражениях) лишь уменьшает бактериемию и временно ослабляет симптомы.
При поражении М. marinum - миноциклин по 100 мг каждые 12 ч в течение 6-8 нед.
При поражении М. kansasii and M. xenopi эффективна стандартная противотуберкулёзная терапия с обязательным назначением рифампицина.
Хирургическое вмешательство рекомендовано при локализованных поражениях у пациентов молодого возраста без патологии других органов и систем.
При лимфадените - у детей от 1 до 5 лет показано хирургическое лечение.
При кожных поражениях, вызванных М. marinum, - тетрациклин (1-2 r/сут) и сочетание рифампицина и этамбутола в течение 3-6 мес.
При инфекциях, вызванных ранами или инородными телами.
Хирургическая обработка раны и удаление инородного тела. Лекарственная терапия: сульфатримоксазол (50 мг/кг сут), доксициклин (200-400 мг/сут), цефокситин (200 мг/кг/ сут), амикацин (10-15 мг/сут) в течение 3-6 мес.
При диссеминированных поражениях - сочетание противотуберкулёзных средств (как при лёгочных поражениях) лишь уменьшает бактериемию и временно ослабляет симптомы.